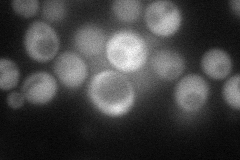
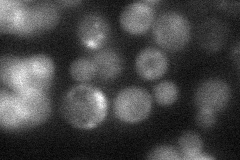
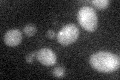

View description
Proteasome-interacting protein involved in the assembly of the base subcomplex of the 19S proteasomal regulatory particle (RP); similar to mammalian proteasomal modulator subunit; non-essential gene; interacts with Rpn4p
Localization:
Intensity:
Fold change:
Significance:
-
C’ GFP library in SD

below threshold16.39 -
N' NOP1pr-GFP in SD
cytosol85.2626 -
N' TEF2pr-mCherry in SD

cytosol108.648 -
N' NATIVEpr-GFP in SD
cytosol24.8444 -
N' TEF2pr-VC and Cyto-VN in SD

#N/A0 -
C’ GFP library in SD+DTT
cytosol17.771.08No -
C’ GFP library in SD+H2O2

cytosol14.620.89No -
C’ GFP library in Starvation Media

cytosol15.150.92No -
C’ GFP library on the background of Pup2-DaMP

N/A -
C’ GFP library on the background of CCT mutant

N/A0N/AYes
